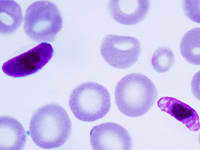

|
Descubren un virus parecido al Ébola en murciélagos de la Península Ibérica
 Martes, 3/11/2009 - 1:48
Martes, 3/11/2009 - 1:48
Investigadores del Instituto de Salud Carlos III han descubierto un virus simular al del Ébola en murciélagos de la PenÃnsula Ibérica.
Leer más...
|
|
Trazado el mapa genómico de un microbio que pulula en zonas muertas del océano
 Sábado, 24/10/2009 - 21:2
Sábado, 24/10/2009 - 21:2
CientÃficos de EEUU y Canadá han trazado la estructura del genoma de un microbio que pulula en zonas muertas de los océanos donde casi no hay oxÃgeno, reveló un estudio difundido hoy por la revista Science.
Leer más...
|
|
El hongo asesino de anfibios
 Sábado, 24/10/2009 - 19:50
Sábado, 24/10/2009 - 19:50
Desde hace un par de décadas un hongo está matando a poblaciones enteras de anfibios. Los biólogos están muy preocupados porque se ha extendido por todo el planeta.
Leer más...
|
|
Hallan microorganismos que podrían explicar el origen de la vida
 Lunes, 19/10/2009 - 0:1
Lunes, 19/10/2009 - 0:1
El hallazgo de aproximadamente tres mil especies de microorganismos prehistóricos, en las pozas de Cuatrociénegas, Coahuila, abre la posibilidad de estudiar el origen de la vida en el planeta, afirmó la genetista del Centro de Investigación y de Estudios Avanzados (Cinvestav), Irapuato, Gabriela Olmedo Alvarez.
Leer más...
|
|
Descubren un mecanismo que permite a las bacterias escapar del sistema inmune
 Miércoles, 14/10/2009 - 0:28
Miércoles, 14/10/2009 - 0:28
CientÃficos del Instituto Pasteur en ParÃs (Francia) y la Universidad de Yale en Estados Unidos han descubierto una vÃa por la que los patógenos intracelulares explotan los atributos biológicos de los organismos que infectan para escapar de su destrucción.
Leer más...
|
|
Descubren el nucléolo más pequeño de la naturaleza
 Lunes, 12/10/2009 - 22:21
Lunes, 12/10/2009 - 22:21
Biólogos de la Facultad de Ciencias (FC) de la UNAM, rompieron un paradigma mundial, al demostrar que el microorganismo Giardia duodenalis sà tiene nucléolo, aunque es tan pequeño, que se ubica en la frontera entre lo que observan los microscópicos ópticos y los electrónicos.
Leer más...
|
|
Descubren en Brasil parásito de la malaria generador de antígenos
Sábado, 10/10/2009 - 16:29
Sábado, 10/10/2009 - 16:29
El parásito que transmite la malaria es capaz de presentarle a los glóbulos rojos del ser humano diferentes familias de antÃgenos, una estrategia que le permite burlar las defensas del organismo, según estudios de investigadores brasileños.
Leer más...
|
|
Un parásito pudo ser un adversario letal para el todopoderoso T.Rex
 Sábado, 3/10/2009 - 22:49
Sábado, 3/10/2009 - 22:49
El famoso Tiranosaurus Rex fosilizado que se conserva en el Field Museum de Chicago, no murió en un colosal combate con otro ejemplar de su especie, sino simplemente por la enfermedad provocada por un diminuto parásito.
Leer más...
|
|
Descubren que el virus del sida ya circulaba hace cien millones de años
 Jueves, 1/10/2009 - 17:52
Jueves, 1/10/2009 - 17:52
CientÃficos norteamericanos hallaron en mamÃferos primitivos un retrovirus de caracterÃsticas extremadamente similares a las del HIV. Este hallazgo permitirá estudiar qué virus pueden pasar de una especie a otra
Leer más...
|
|
Descubren una nueva bacteria en Altamira
 Miércoles, 23/9/2009 - 1:51
Miércoles, 23/9/2009 - 1:51
Un grupo de investigadores del Instituto de Recursos Naturales y AgrobiologÃa de Sevilla (Irnas) del Consejo Superior de Invstigaciones CientÃficas (CSIC) ha descubierto un nuevo género de bacterias del orden 'Actinomycetales' en Altamira (Cantabria).
Leer más...
|
|
Científicos descubren cómo las bacterias se adaptan a los cambios ambientales
 Lunes, 21/9/2009 - 7:45
Lunes, 21/9/2009 - 7:45
Los autores han sugerido, además, que el mecanismo podrÃa servir incluso para que las bacterias de una especie detecten la presencia de otras especies, «y responder adecuadamente a ello».
Leer más...
|
|
Nuevo estudio explica la resistencia de las bacterias a los antibióticos
 Domingo, 13/9/2009 - 11:26
Domingo, 13/9/2009 - 11:26
Una pequeña molécula compuesta de un átomo de oxÃgeno y uno de nitrógeno juega un papel importante a la hora de ayudar a los patógenos a resistir a los antibióticos, según un nuevo estudio divulgado en la revista Science.
Leer más...
|
|
La piel, un hogar para las bacterias
 Lunes, 1/6/2009 - 13:15
Lunes, 1/6/2009 - 13:15
En la epidermis existe más variedad de comunidades microbianas de lo que se pensaba. Las pieles secas y húmedas son las que más diversidad de bacterias albergan.
Leer más...
|
|
Descubren científicos nuevo virus mortal parecido al Ébola
 Sábado, 30/5/2009 - 9:54
Sábado, 30/5/2009 - 9:54
CientÃficos en Estados Unidos identificaron un nuevo virus mortal en Africa que hace que sus vÃctimas sangren igual que quienes sufren el temido virus Ebola.
Leer más...
|
|
6 |







